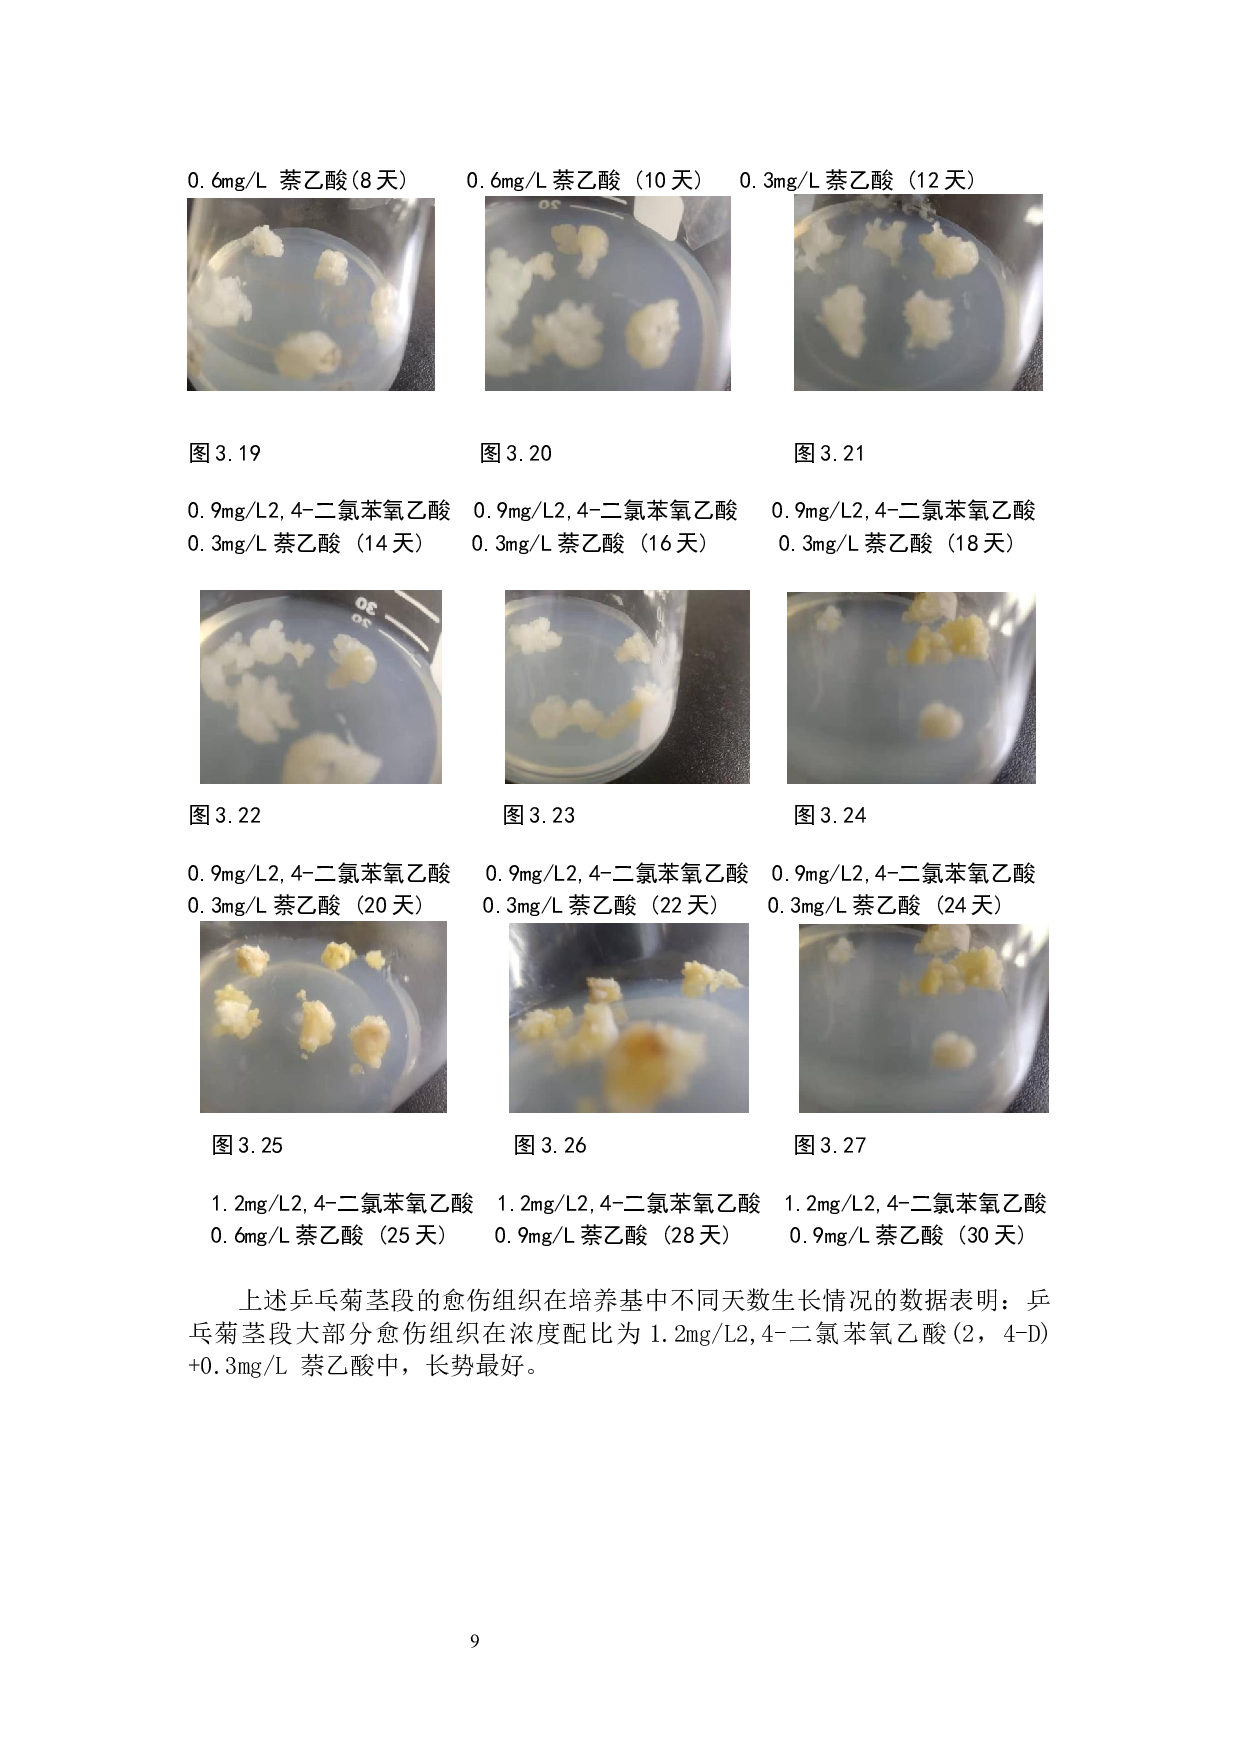
不同激素浓度对乒乓菊愈伤组织形成的影响研究-6481字.docx 第8页

摘
要
为以乒乓菊的茎尖和花瓣为外植体, 每瓶培养基均含浓度为2.5mg/L的6-
BA
对乒乓菊愈伤组织诱导的影响,
以期为盆栽菊花的批量化或其他类型菊花(切花型菊花或造型菊花等)组织培养快速繁殖技术等的研究提供重要的参考
。在该试验设计的浓度范围内结果表明:不同激素浓度诱导不同部位的外植体存在差异。以乒乓菊的花瓣为外植体进行诱导培养,确定乒乓菊花瓣诱导培养最佳培养基激素配比为MS+2.5mg/L的6-BA+1.2mg/L2,4-二氯苯氧乙酸(2,4-D) +0.3mg/L 萘乙酸(NAA)。以乒乓菊的茎尖为外植体进行诱导培养,确定乒乓菊茎尖诱导培养最佳培
不同激素浓度对乒乓菊愈伤组织形成的影响研究-6481字.docx